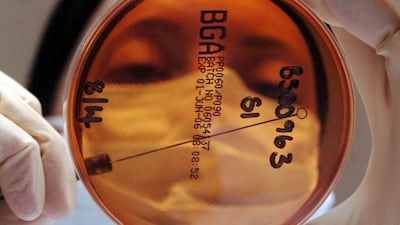
Norovirus cases have been surging in recent weeks. PA

Cases of norovirus across the country are “the highest we have seen at this time of year in over a decade”, a doctor at the UK Health Security Agency has warned.
Levels of the highly infectious stomach bug have been surging in recent weeks, with hundreds of hospital beds filled by people with symptoms, figures show.
Norovirus cases are more than double the five-season average before the coronavirus pandemic, the UKHSA said.
Reporting has increased across all age groups, most notably in those aged 65 and over.
While most of the outbreaks caused by norovirus continue to be reported in care homes, cases in hospitals are also increasing but remain below the five-season average.
Outbreaks reported in care home settings increased from 47 in the week starting on February 6 to 54 in the week beginning February 13, representing the highest number reported in a week so far this season.
Top 10 probiotic foods that help improve gut health - in pictures
Dr Lesley Larkin, surveillance lead of gastrointestinal infections and food safety at UKHSA, said the increase represents “the highest [levels] we have seen at this time of year” in more than 10 years.
The National Health Service says symptoms of norovirus — also known as the “winter vomiting bug” — include diarrhoea and feeling or being sick.
Those infected may also experience a high temperature, headaches and aching arms and legs.
Norovirus is highly infectious and easily spread through contact with someone with the infection or contaminated surfaces.
Most people will make a full recovery within two to three days, but the agency urges those with the illness to drink plenty of fluids to prevent dehydration, especially the very young, elderly or those with weakened immune systems.
Fermented foods for gut health - in pictures
“Please stay at home if you are experiencing norovirus symptoms and don’t return to work [particularly if you work with vulnerable people or food], or send sick children to school or nursery until 48 hours after symptoms have cleared," Dr Larkin said.
“If you have a loved one in a care home or hospital, please avoid visiting until 48 hours after symptoms have cleared.
“Regular hand washing is really important to help stop the spread of this bug, but remember, alcohol gels do not kill off norovirus so washing with soap and warm water is best.”